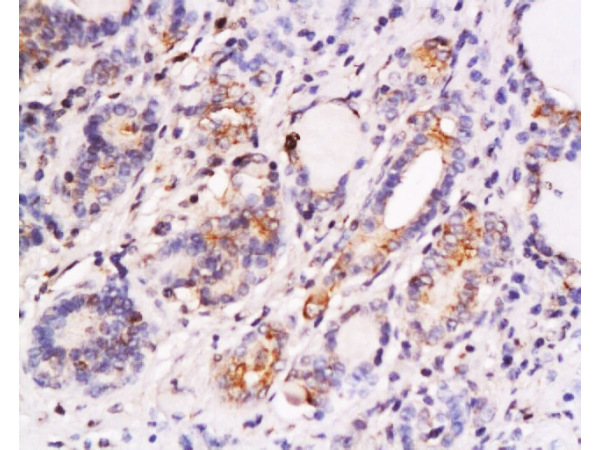

MCF-7 cells were stained with SKP2 Polyclonal Antibody, Unconjugated(bs-1096R) at 1:500 in PBS and incubated for two hours at 37°C followed by Goat Anti-Rabbit IgG (H+L) Cy3 conjugated secondary antibody. DAPI staining of the nucleus was done and then detected.
SKP2 Polyclonal Antibody
BS-1096R
ApplicationsFlow Cytometry, ImmunoFluorescence, Western Blot, ELISA, ImmunoCytoChemistry, ImmunoHistoChemistry, ImmunoHistoChemistry Frozen, ImmunoHistoChemistry Paraffin
Product group Antibodies
TargetSKP2
Overview
- SupplierBioss
- Product NameSKP2 Polyclonal Antibody
- Delivery Days Customer16
- ApplicationsFlow Cytometry, ImmunoFluorescence, Western Blot, ELISA, ImmunoCytoChemistry, ImmunoHistoChemistry, ImmunoHistoChemistry Frozen, ImmunoHistoChemistry Paraffin
- Applications SupplierWB(1:300-5000), ELISA(1:500-1000), FCM(1:20-100), IHC-P(1:200-400), IHC-F(1:100-500), IF(IHC-P)(1:50-200), IF(IHC-F)(1:50-200), IF(ICC)(1:50-200)
- CertificationResearch Use Only
- ClonalityPolyclonal
- Concentration1 ug/ul
- ConjugateUnconjugated
- Gene ID6502
- Target nameSKP2
- Target descriptionS-phase kinase associated protein 2
- Target synonymsFBL1, FBXL1, FLB1, p45, S-phase kinase-associated protein 2, CDK2/cyclin A-associated protein p45, F-box/LRR-repeat protein 1, S-phase kinase-associated protein 2, E3 ubiquitin protein ligase, p45skp2
- HostRabbit
- IsotypeIgG
- Protein IDQ13309
- Protein NameS-phase kinase-associated protein 2
- Storage Instruction-20°C
- UNSPSC12352203
References
- Pan Y, Li G, Zhong H, et al. RIG-I inhibits pancreatic β cell proliferation through competitive binding of activated Src. Sci Rep. 2016,6:28914. doi: 10.1038/srep28914Read this paper